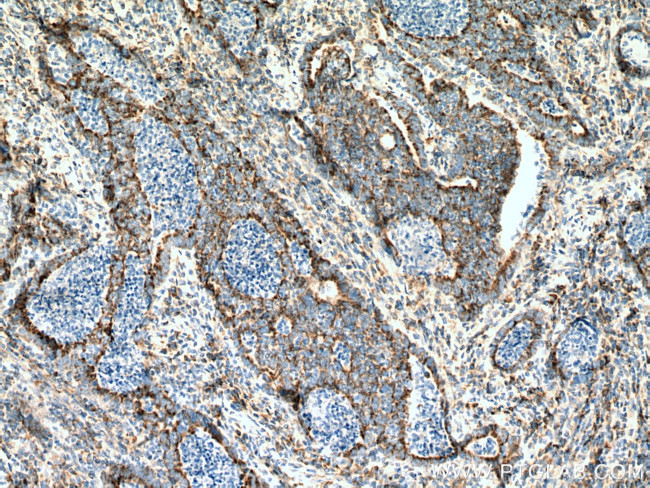
SUCLG2 Antibody in Immunohistochemistry (Paraffin) (IHC (P))

Search
Proteintech
SUCLG2 Polyclonal Antibody
{{$productOrderCtrl.translations['antibody.pdp.commerceCard.promotion.promotions']}}
{{$productOrderCtrl.translations['antibody.pdp.commerceCard.promotion.viewpromo']}}
{{$productOrderCtrl.translations['antibody.pdp.commerceCard.promotion.promocode']}}: {{promo.promoCode}} {{promo.promoTitle}} {{promo.promoDescription}}. {{$productOrderCtrl.translations['antibody.pdp.commerceCard.promotion.learnmore']}}
产品信息
14240-1-AP
种属反应
宿主/亚型
分类
类型
抗原
偶联物
形式
浓度
规格
纯化类型
保存液
内含物
保存条件
运输条件
产品详细信息
Immunogen sequence: MSDNGVRVQ RFFVADTANE ALEAAKRLNA KEIVLKAQIL AGGRGKGVFN SGLKGGVHLT KDPNVVGQLA KQMIGYNLAT KQTPKEGVKV NKVMVAEALD ISRETYLAIL MDRSCNGPVL VGSPQGGVDI EEVAASNPEL IFKEQIDIFE GIKDSQAQRM AENLGFVGPL KSQAADQITK LYNLFLKIDA TQVEVNPFGE TPEGQVVCFD AKINFDDNAE FRQKDIFAMD DKSENEPIEN EAAKYDLKYI GLDGNIACFV NGAGLAMATC DIIFLNGGKP ANFLDLGGGV KEAQVYQAFK LLTADPKVEA ILVNIFGGIV NCAIIANGIT KACRELELKV PLVVRLEGTN VQEAQKILNN SGLPITSAID LEDAAKKAVA SVAKK (1-385 aa encoded by BC047024)
靶标信息
This gene encodes a GTP-specific beta subunit of succinyl-CoA synthetase. Succinyl-CoA synthetase catalyzes the reversible reaction involving the formation of succinyl-CoA and succinate. Alternate splicing results in multiple transcript variants. Pseudogenes of this gene are found on chromosomes 5 and 12.
仅用于科研。不用于诊断过程。未经明确授权不得转售。
生物信息学
蛋白别名: G-BETA; G-SCS; GTP-specific succinyl-CoA synthetase beta subunit; GTP-specific succinyl-CoA synthetase subunit beta; Itaconyl--CoA ligase [GDP-forming] subunit beta; Malyl--CoA ligase [GDP-forming] subunit beta; SCS-betaG; Succinate--CoA ligase [GDP-forming] subunit beta, mitochondrial; succinate-CoA ligase GDP-forming beta subunit; succinate-Coenzyme A ligase, GDP-forming, beta subunit; succinyl-CoA ligase [GDP-forming] subunit beta, mitochondrial; succinyl-CoA ligase, GDP-forming, beta chain, mitochondrial; Succinyl-CoA synthetase beta-G chain; succinyl-CoA synthetase, beta-G chain; unnamed protein product
基因别名: AF171077; AW556404; D6Wsu120e; G-SCS; GBETA; GTPSCS; SCS-betaG; SUCLG2
UniProt ID: (Human) Q96I99, (Mouse) Q9Z2I8
Entrez Gene ID: (Human) 8801, (Mouse) 20917, (Rat) 362404